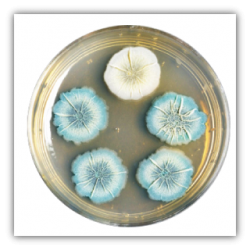

Odelia Siboni
Carbon Dioxide precipitation by bacterial biofilms
In my PhD research I aim to clarify the different roles played by the different extracellular scaffolds in the process of calcite production in undomesticated Bacillus subtilis.
![]() |
| Purified Calcite from bacterial colony examined using scanning electron microscope (SEM). The rods on the left are “scars” of the bacteria reside within the calcite. |